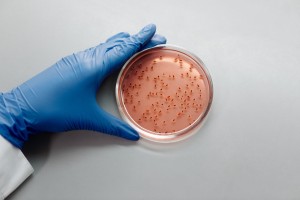
Zika Virüsü

Annelik ve Gebelik" kategorisi, anne adayları ve hamile kadınlar için bilgilendirici ve destekleyici içerikler sunan bir alanı kapsar. Bu kategori, gebelik sürecindeki değişimleri, anne sağlığını, doğum öncesi ve sonrası bakımı, bebek gelişimi ve anneliğe dair pek çok konuyu kapsar. İçerikler, anne adaylarına gebelik sürecinde karşılaşabilecekleri sorunlar, yaşadıkları duygusal değişimler ve sağlıklı bir gebelik geçirmek için alınabilecek önlemler hakkında bilgi sunar.
Bu kategorideki içerikler arasında, gebelik belirtileri, doğru beslenme, prenatal bakım, hamilelik dönemindeki egzersiz önerileri gibi konulara odaklanan makaleler bulunur. Aynı zamanda, doğum öncesi hazırlık, doğum planlaması, doğum sonrası bakım ve emzirme gibi konuları da ele alan içerikler bu kategori içinde yer alır.
Gebelik sürecinin yanı sıra, anneliğe geçiş süreci, bebek bakımı, ebeveynlik becerileri ve çocuk gelişimi konuları da bu kategoride geniş bir şekilde ele alınır. Anne adaylarına ve yeni annelere rehberlik etmek, sorularına cevap vermek ve sağlıklı bir anne-bebek ilişkisi kurmalarına yardımcı olmak amacıyla hazırlanan içerikler, "Annelik ve Gebelik" kategorisinin temelini oluşturur.